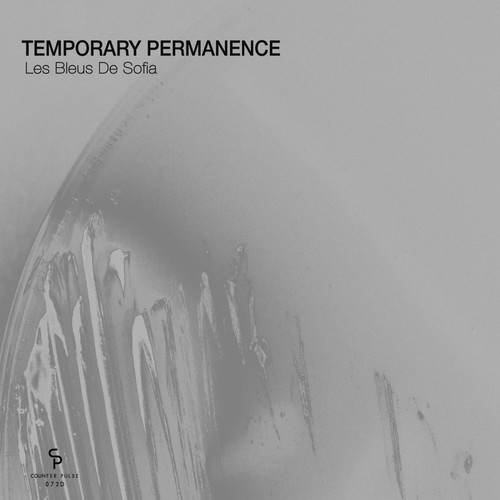
Les Bleus De Sofia

当前位置:首页 >> Les Bleus De Sofia >> 歌曲列表 第1页
Les Bleus De Sofia
专辑歌曲列表
共有4首
-
Temporary Permanence 6.77 MB 07:23
-
Temporary Permanence 6.94 MB 07:34
-
Temporary Permanence 6.89 MB 07:31
-
Temporary Permanence 6.66 MB 07:16

